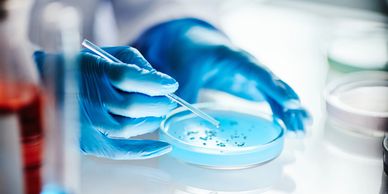

Products
Antibiotics / Selective agents
Antibiotics / Selective agents
Antibiotics / Selective agents

Discover Our Top Product
PEPP is designed by Plant Biotechnologies using natural plant extracts to protect plant from bacterial, fungal without using antibiotics